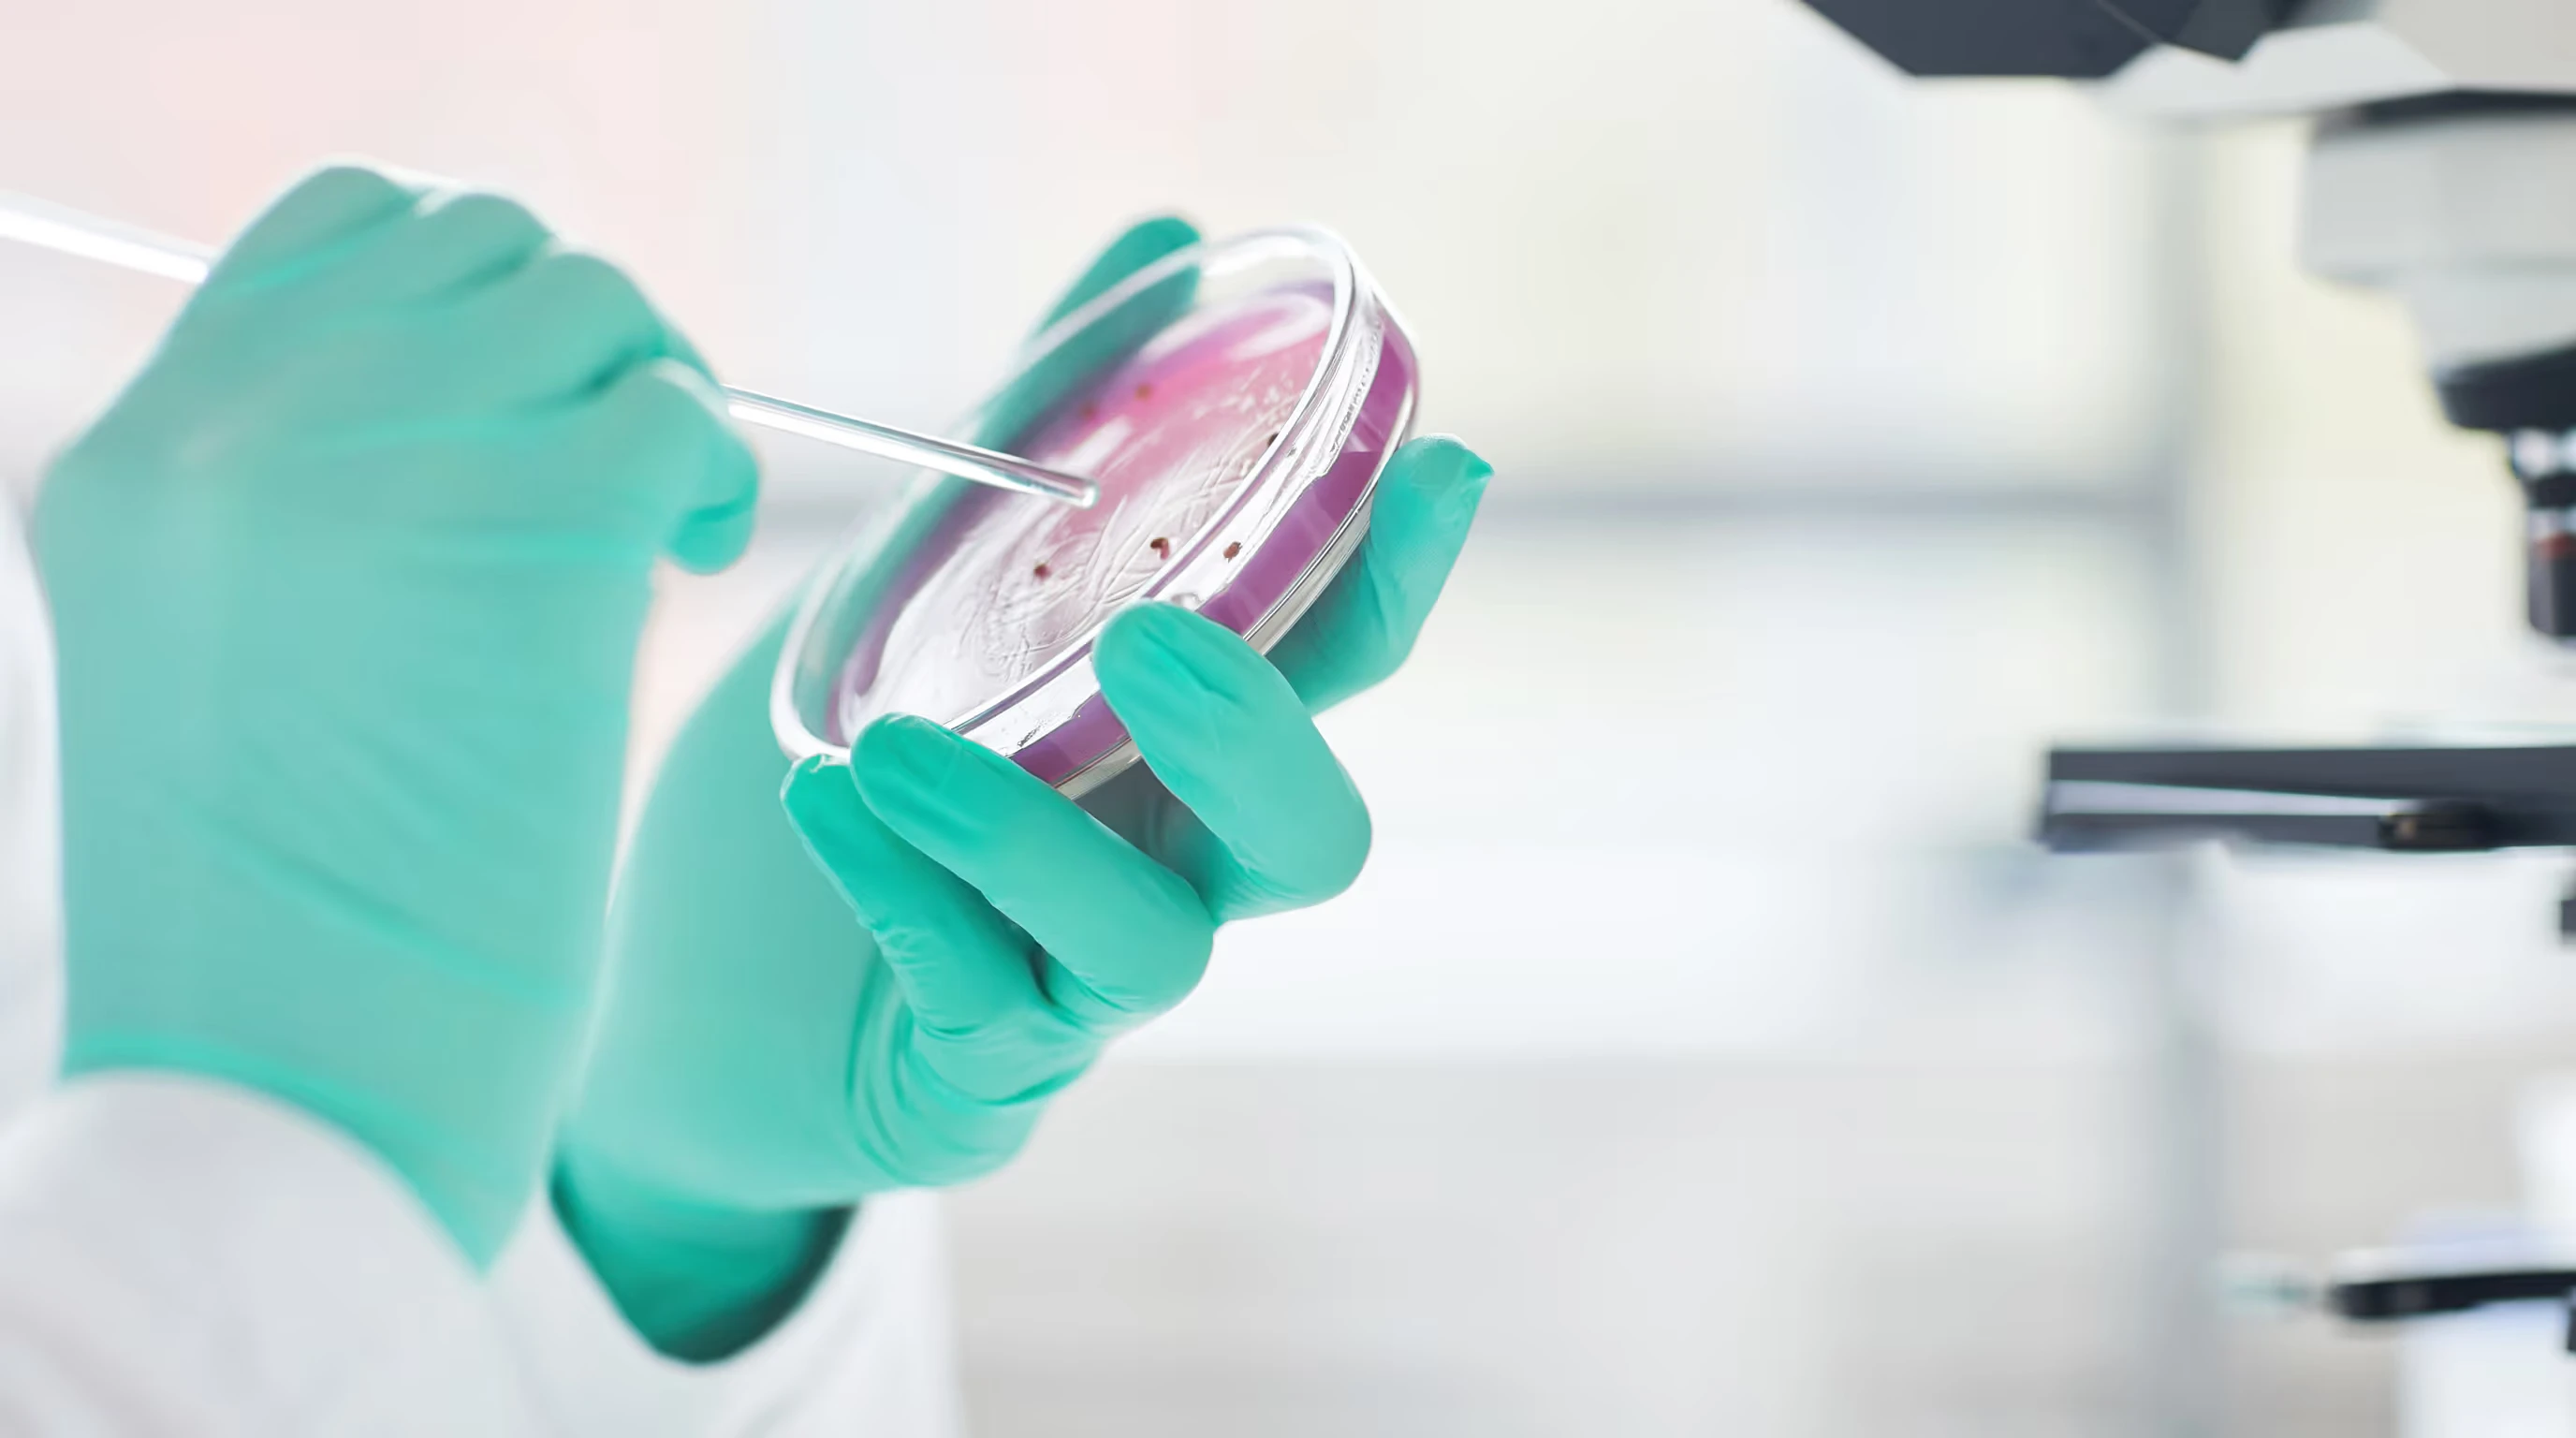

Design of a Scalable Healthcare Analytics Platform
Surgo Health is a Canadian health-tech organization that transitioned from a non-profit consultancy model into a product-driven SaaS company, with a clear focus on enabling better decision-making in healthcare through data.
As part of this evolution, the organization needed a robust and scalable analytics platform capable of handling large volumes of fragmented healthcare data alongside social determinants of health. Their goal was not just to centralize data, but to make it meaningful, accessible, and actionable for a wide range of users including healthcare providers, researchers, and policy teams.
To support this vision, we partnered with Surgo Health to design a modern analytics experience that could simplify complex datasets without compromising analytical depth. The challenge was to bring together multiple data sources into a single cohesive platform while ensuring that users could easily interpret patterns, compare regions and population segments, and derive insights that directly support strategic and operational decisions. The platform was carefully structured to accommodate both technical users who require detailed data exploration and non-technical stakeholders who need clear, high-level insights.
Built using React JS and Material UI, and developed through over 1900+ hours of focused design effort by a dedicated team, the solution emphasizes clarity, usability, and scalability. The interface was designed to reduce cognitive load through intuitive layouts, meaningful visual hierarchies, and insight-first dashboards that guide users toward key findings. By aligning design decisions with real-world healthcare workflows and user needs, the platform enables teams to move from raw data to informed action more efficiently.

We designed a scalable healthcare analytics platform built to support real-world decision-making across complex care environments. The platform translates vast and fragmented healthcare data, including clinical and social determinants of health, into clear, actionable insights that teams can confidently use. By enabling seamless comparison across regions, conditions, and diverse population segments, it helps organizations identify patterns, gaps, and opportunities for intervention. At the same time, the experience is carefully structured to serve both technical analysts and non-technical stakeholders, ensuring that everyone—from data teams to leadership—can explore, understand, and act on the insights without friction.

test
Turning Data Complexity into Usable Insights
One of the core challenges was managing and visualizing large volumes of multidimensional data without overwhelming the user. The platform needed to present deep analytical insights while maintaining clarity and ease of use, striking the right balance between complexity and simplicity. We focused on designing an interface that remains intuitive and approachable for a wide range of user roles—from data analysts to decision-makers—each with different levels of technical expertise. Additionally, integrating data from multiple sources into a single, cohesive experience required careful structuring, ensuring consistency, reliability, and seamless navigation across the platform.

test
Our work followed a User-Centered Design (UCD) methodology, shaped around understanding user needs, validating decisions with research, and adapting to real healthcare constraints. This process ensured that each design decision was validated, user-focused, and aligned with deeper organizational goals.
The Realization of Technological Excellence
The final product reflects a strong alignment between user needs, data complexity, and thoughtful design execution. Through user research, structured workflows, and continuous iteration, the platform evolved into an insight-driven experience that simplifies how healthcare data is explored and understood. Dashboards are designed to reduce cognitive load and surface meaningful patterns quickly, while interactive comparison views allow users to analyze regions, demographics, and risk classifications with clarity. A well-defined visual hierarchy enhances confidence in the data, and the platform’s scalable architecture ensures it can support future expansion, advanced analytics modules, and growing datasets.

test
Like this project
Posted Mar 30, 2026
Designed a scalable analytics platform for healthcare data decision-making.
Likes
0
Views
0
Clients

Surgo Health








